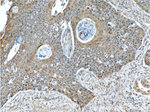
JIP1 Antibody in Immunohistochemistry (Paraffin) (IHC (P))

Search
Proteintech
JIP1 Polyclonal Antibody
{{$productOrderCtrl.translations['antibody.pdp.commerceCard.promotion.promotions']}}
{{$productOrderCtrl.translations['antibody.pdp.commerceCard.promotion.viewpromo']}}
{{$productOrderCtrl.translations['antibody.pdp.commerceCard.promotion.promocode']}}: {{promo.promoCode}} {{promo.promoTitle}} {{promo.promoDescription}}. {{$productOrderCtrl.translations['antibody.pdp.commerceCard.promotion.learnmore']}}
产品信息
14568-1-AP
种属反应
宿主/亚型
分类
类型
抗原
偶联物
形式
浓度
规格
纯化类型
保存液
内含物
保存条件
运输条件
产品详细信息
Immunogen sequence: SLSSDTSAL SYDSVKYTLV VDEHAQLELV SLRPCFGDYS DESDSATVYD NCASVSSPYE SAIGEEYEEA PRPQPPACLS EDSTPDEPDV HFSKKFLNVF MSGRSRSSSA ESFGLFSCII NGEEQEQTHR AIFRFVPRHE DELELEVDDP LLVELQAEDY WYEAYNMRTG ARGVFPAYYA IEVTKEPEHM AALAKNSDWV DQFRVKFLGS VQVPYHKGND VLCAAMQKIA TTRRLTVHFN PPSSCVLEIN VRGVKIGVKA DDSQEAKGNK CSHFFQLKNI SFCGYHPKNN KYFGFITKHP ADNRFACHVF VSEDSTKALA ESVGRAFQQF YKQFVEYTCP TEDIYLE (366-711 aa encoded by BC068470 )
靶标信息
The protein encoded by this gene is a regulator of the pancreatic beta-cell function. It is highly similar to JIP-1, a mouse protein known to be a regulator of c-Jun amino-terminal kinase (Mapk8). This protein has been shown to prevent MAPK8 mediated activation of transcription factors, and decrease IL-1 beta and MAP kinase kinase 1 (MEKK1) induced apoptosis in pancreatic beta cells. This protein also functions as a DNA-binding transactivator of the glucose transporter GLUT2. RE1-silencing transcription factor (REST) is reported to repress the expression of this gene in insulin-secreting beta cells. This gene is found to be mutated in a type 2 diabetes family, and thus is thought to be a susceptibility gene for type 2 diabetes.
仅用于科研。不用于诊断过程。未经明确授权不得转售。
生物信息学
蛋白别名: C-Jun-amino-terminal kinase-interacting protein 1; IB-1; IB1; C-jun-amino-terminal kinase interacting protein-1 JIP-1; Islet-brain 1; Islet-brain-1; JIP-1; JIP-1-related protein; JNK MAP kinase scaffold protein 1; JNK-interacting protein 1; JRP; mitogen activated protein kinase 8 interacting protein; mitogen activated protein kinase 8 interacting protein 1; Mitogen-activated protein kinase 8-interacting protein 1; PRKM8 interacting protein; protein kinase, mitogen-activated 8 interacting protein; unnamed protein product
基因别名: IB1; JIP-1; JIP1; Mapk8ip; MAPK8IP1; mjip-2a; PRKM8IP; Skip
UniProt ID: (Human) Q9UQF2, (Rat) Q9R237, (Mouse) Q9WVI9
Entrez Gene ID: (Human) 9479, (Rat) 116457, (Mouse) 19099